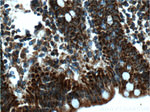
ME2 Antibody in Immunohistochemistry (Paraffin) (IHC (P))

Search
Proteintech
ME2 Polyclonal Antibody
{{$productOrderCtrl.translations['antibody.pdp.commerceCard.promotion.promotions']}}
{{$productOrderCtrl.translations['antibody.pdp.commerceCard.promotion.viewpromo']}}
{{$productOrderCtrl.translations['antibody.pdp.commerceCard.promotion.promocode']}}: {{promo.promoCode}} {{promo.promoTitle}} {{promo.promoDescription}}. {{$productOrderCtrl.translations['antibody.pdp.commerceCard.promotion.learnmore']}}
产品信息
24944-1-AP
种属反应
已发表种属
宿主/亚型
分类
类型
抗原
偶联物
形式
浓度
规格
纯化类型
保存液
内含物
保存条件
运输条件
产品详细信息
Immunogen sequence: SISDRGHVR SIVDNWPENH VKAVVVTDGE RILGLGDLGV YGMGIPVGKL CLYTACAGIR PDRCLPVCID VGTDNIALLK DPFYMGLYQK RDRTQQYDDL IDEFMKAITD RYGRNTLIQF EDFGNHNAFR FLRKYREKYC TFNDDIQGTA AVALAGLLAA QKVISKPISE HKILFLGAGE AALGIANLIV MSMVENGLSE QEAQKKIWMF DKYGLLVKGR KAKIDSYQEP FTHSAPESIP DTFEDAVNIL KPSTIIGVAG AGRLFTPDVI RAMASINERP VIFALSNPTA QAECTAEEAY TLTEGRCLFA SGSPFGPVKL TDGRVFTPGQ GNNVYIFPGY RIPIC (136-480 aa encoded by BC000147)
靶标信息
ME2 encodes a mitochondrial NAD-dependent malic enzyme, a homotetrameric protein, that catalyzes the oxidative decarboxylation of malate to pyruvate. It had previously been weakly linked to a syndrome known as Friedreich ataxia that has since been shown to be the result of mutation in a completely different gene. Certain single-nucleotide polymorphism haplotypes of this gene have been shown to increase the risk for idiopathic generalized epilepsy. Alternatively spliced transcript variants encoding different isoforms found for this gene.
仅用于科研。不用于诊断过程。未经明确授权不得转售。
生物信息学
蛋白别名: malate dehydrogenase (oxaloacetate-decarboxylating); Malic enzyme 2; malic enzyme 2, NAD(+)-dependent, mitochondrial; NAD-dependent malic enzyme, mitochondrial; NAD-ME; pyruvic-malic carboxylase; unnamed protein product
基因别名: ME2; ODS1
UniProt ID: (Human) P23368
Entrez Gene ID: (Human) 4200